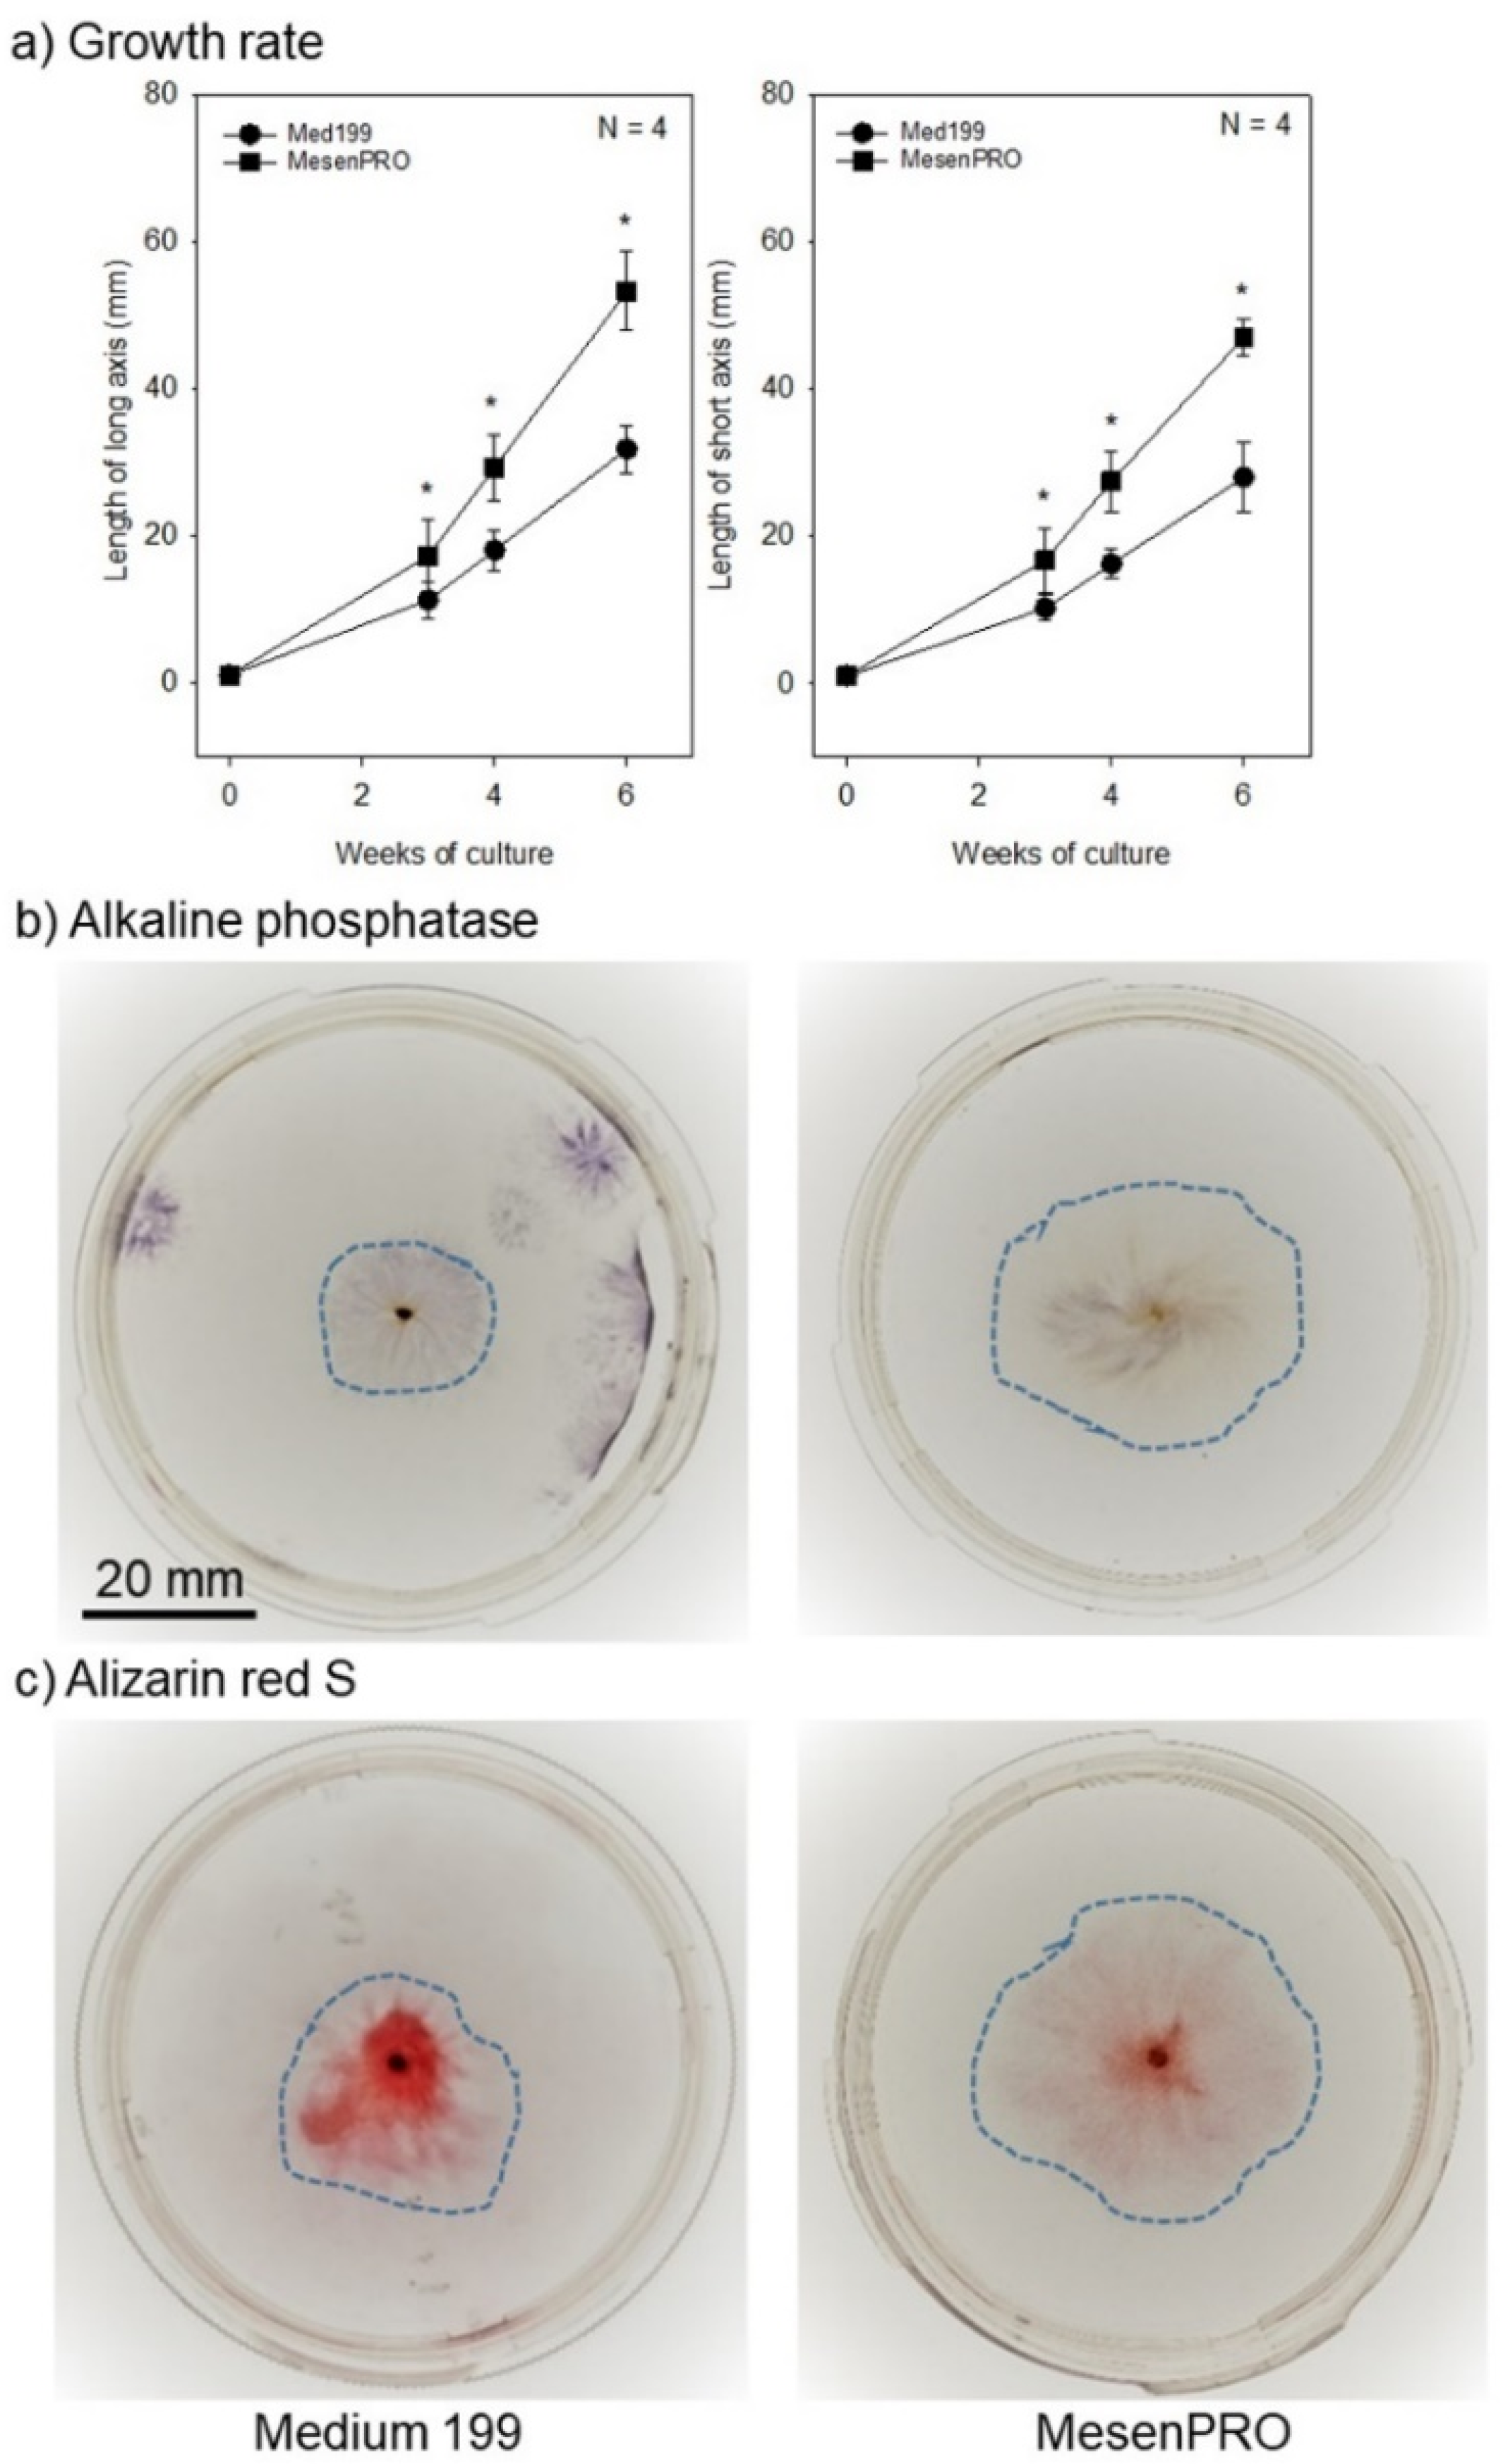
Ijms 22 02169 g002

Osteoclastogenic Potential of Tissue-Engineered Periosteal Sheet: Effects of Culture Media on the Ability to Recruit Osteoclast Precursors
Abstract
:1. Introduction
2. Results
2.1. In Vitro Studies
2.2. In Vivo Studies
3. Discussion
3.1. General Outlook
3.2. Recruitment of BM Cells
3.3. Osteoclast Formation
3.4. Characterization and Limitations of Bone Marrow (BM) Chimeric Nude Mice
4. Clinical Relevance
5. Materials and Methods
5.1. Preparation of Tissue-Engineered Periosteal Sheets (TPSs)
5.2. Bone Marrow Transplantation (BMT)
5.3. Hematology and Flow-Cytometry
5.4. Tissue-Engineered Periosteal Sheet (TPS) Implantation into the Bone Marrow-Transplanted Mice
5.5. Quantitative Real-Time Polymerase Chain Reaction (qPCR)
5.6. Histological and Immunohistochemical Examination
5.7. Image Analysis
5.8. Statistical Analysis
6. Conclusions
Supplementary Materials
Author Contributions
Funding
Institutional Review Board Statement
Informed Consent Statement
Data Availability Statement
Acknowledgments
Conflicts of Interest
Abbreviations
| ALP | Alkaline phosphatase |
| ARS | Alizarin red S |
| BM | Bone marrow |
| BMP | Bone morphogenetic protein |
| BMT | Bone marrow transplantation |
| CAG | Cytomegalovirus early enhancer/chicken β actin |
| CCL | Chemokine (C-C motif) ligand |
| CSF-1 | Colony-stimulating factor-1 |
| EGFP | Enhanced green fluorescent protein |
| FBS | Fetal bovine serum |
| GFP | Green fluorescent protein |
| HRP | Horseradish peroxidase |
| M-CSF | Macrophage-colony stimulating factor |
| MNC | Mononuclear cell |
| MSC | Mesenchymal stem cell |
| qPCR | Quantitative real-time polymerase chain reaction |
| PRFext | Platelet-rich fibrin extract |
| RANKL | Receptor activator of nuclear factor-kappa B ligand |
| SDF-1 | Stromal cell-derived factor-1 |
| TBS | Tris-buffered saline |
| TGF-β | Transforming growth factor-β |
| TPS | Tissue-engineered periosteal sheet |
| TRAP | Tartrate-resistant acid phosphatase |
References
- O’Driscoll, S.W. Articular cartilage regeneration using periosteum. Clin. Orthop. Relat. Res. 1999, 367, S186–S203. [Google Scholar] [CrossRef] [PubMed]
- Mizuno, H.; Hata, K.; Kojima, K.; Bonassar, L.J.; Vacanti, C.A.; Ueda, M. A novel approach to regenerating periodontal tissue by grafting autologous cultured periosteum. Tissue Eng. 2006, 12, 1227–1335. [Google Scholar] [CrossRef]
- Okuda, K.; Kawase, T.; Nagata, M.; Yamamiya, K.; Nakata, K.; Wolff, L.F.; Yoshie, H. Tissue-engineered cultured periosteum sheet application to treat infrabony defects: Case series and 5-year results. Int. J. Periodont. Rest. Dent. 2013, 33, 281–287. [Google Scholar] [CrossRef] [PubMed]
- Okuda, K.; Yamamiya, K.; Kawase, T.; Mizuno, H.; Ueda, M.; Yoshie, H. Treatment of human infrabony periodontal defects by grafting human cultured periosteum sheets combined with platelet-rich plasma and porous hydroxyapatite granules: Case series. J. Int. Acad. Periodontol. 2009, 11, 206–213. [Google Scholar]
- Yamamiya, K.; Okuda, K.; Kawase, T.; Hata, K.; Wolff, L.F.; Yoshie, H. Tissue-engineered cultured periosteum used with platelet-rich plasma and hydroxyapatite in treating human osseous defects. J. Periodontol. 2008, 79, 811–818. [Google Scholar] [CrossRef]
- Kawase, T.; Tanaka, T.; Nishimoto, T.; Okuda, K.; Nagata, M.; Burns, D.M.; Yoshie, H. An osteogenic grafting complex combining human periosteal sheets with a porous poly(l-lactic acid) membrane scaffold: Biocompatibility, biodegradability, and cell fate in vivo. J. Bioact. Compat. Polymers. 2012, 27, 107–121. [Google Scholar] [CrossRef]
- Uematsu, K.; Kawase, T.; Nagata, M.; Suzuki, K.; Okuda, K.; Yoshie, H.; Burns, D.M.; Takagi, R. Tissue culture of human alveolar periosteal sheets using a stem-cell culture medium (MesenPRO-RS): In vitro expansion of CD146-positive cells and concomitant upregulation of osteogenic potential in vivo. Stem Cell Res. 2013, 10, 1–19. [Google Scholar] [CrossRef] [PubMed] [Green Version]
- Kawase, T.; Okuda, K.; Kogami, H.; Nakayama, H.; Nagata, M.; Nakata, K.; Yoshie, H. Characterization of human cultured periosteal sheets expressing bone-forming potential: In vitro and in vivo animal studies. J. Tissue Eng. Regen. Med. 2009, 3, 218–229. [Google Scholar] [CrossRef]
- Kawase, T.; Okuda, K.; Kogami, H.; Nakayama, H.; Nagata, M.; Yoshie, H. Osteogenic activity of human periosteal sheets cultured on salmon collagen-coated ePTFE meshes. J. Mater. Sci. Mater. Med. 2010, 21, 731–739. [Google Scholar] [CrossRef]
- Kawase, T.; Kogami, H.; Nagata, M.; Uematsu, K.; Okuda, K.; Burns, D.M.; Yoshie, H. Manual cryopreservation of human alveolar periosteal tissue segments: Effects of pre-culture on recovery rate. Cryobiology 2011, 62, 202–209. [Google Scholar] [CrossRef]
- Bar-Shavit, Z. The osteoclast: A multinucleated, hematopoietic-origin, bone-resorbing osteoimmune cell. J. Cell. Biochem. 2007, 102, 1130–1139. [Google Scholar] [CrossRef]
- Edwards, J.R.; Mundy, G.R. Advances in osteoclast biology: Old findings and new insights from mouse models. Nat. Rev. Rheumatol. 2011, 7, 235–243. [Google Scholar] [CrossRef]
- Nagata, M.; Hoshina, H.; Li, M.; Arasawa, M.; Uematsu, K.; Ogawa, S.; Yamada, K.; Kawase, T.; Suzuki, K.; Ogose, A.; et al. A clinical study of alveolar bone tissue engineering with cultured autogenous periosteal cells: Coordinated activation of bone formation and resorption. Bone 2012, 50, 1123–1129. [Google Scholar] [CrossRef] [PubMed]
- Ogawa, S.; Hoshina, H.; Nakata, K.; Yamada, K.; Uematsu, K.; Kawase, T.; Takagi, R.; Nagata, M. High-Resolution Three-Dimensional Computed Tomography Analysis of the Clinical Efficacy of Cultured Autogenous Periosteal Cells in Sinus Lift Bone Grafting. Clin. Implant. Dent. Relat. Res. 2016, 18, 707–716. [Google Scholar] [CrossRef]
- Kawase, T.; Okuda, K. Comprehensive Quality Control of the Regenerative Therapy Using Platelet Concentrates: The Current Situation and Prospects in Japan. BioMed. Res. Int. 2018, 2018, 6389157. [Google Scholar] [CrossRef]
- Uematsu, K.; Nagata, M.; Kawase, T.; Suzuki, K.; Takagi, R. Application of stem-cell media to explant culture of human periosteum: An optimal approach for preparing osteogenic cell material. J. Tissue Eng. 2013, 4, 2041731413509646. [Google Scholar] [CrossRef]
- Rodan, G.A. Bone homeostasis. Proc. Natl. Acad. Sci. USA 1998, 95, 13361–13362. [Google Scholar] [CrossRef] [Green Version]
- Bohner, M.; Santoni, B.L.G.; Döbelin, N. β-tricalcium phosphate for bone substitution: Synthesis and properties. Acta Biomaterialia 2020, 113, 23–41. [Google Scholar] [CrossRef]
- Liu, B.; Lun, D.X. Current application of β-tricalcium phosphate composites in orthopaedics. Orthop. Surg. 2012, 4, 139–144. [Google Scholar] [CrossRef]
- Park, J.H.; Lee, N.K.; Lee, S.Y. Current Understanding of RANK Signaling in Osteoclast Differentiation and Maturation. Mol. Cells 2017, 40, 706–713. [Google Scholar]
- Wu, M.; Chen, G.; Li, Y.-P. TGF-β and BMP signaling in osteoblast, skeletal development, and bone formation, homeostasis and disease. Bone Res. 2016, 4, 16009. [Google Scholar] [CrossRef]
- Lian, N.; Lin, T.; Liu, W.; Wang, W.; Li, L.; Sun, S.; Nyman, J.S.; Yang, X. Transforming growth factor β suppresses osteoblast differentiation via the vimentin activating transcription factor 4 (ATF4) axis. J. Biol. Chem. 2012, 287, 35975–35984. [Google Scholar] [CrossRef] [PubMed] [Green Version]
- Fitzpatrick, V.; Fourel, L.; Destaing, O.; Gilde, F.; Albigès-Rizo, C.; Picart, C.; Boudou, T. Signal mingle: Micropatterns of BMP-2 and fibronectin on soft biopolymeric films regulate myoblast shape and SMAD signaling. Sci. Rep. 2017, 7, 41479. [Google Scholar] [CrossRef] [PubMed]
- Geiger, M.; Li, R.H.; Friess, W. Collagen sponges for bone regeneration with rhBMP-2. Adv. Drug Deliv. Rev. 2003, 55, 1613–1629. [Google Scholar] [CrossRef] [PubMed]
- Kawase, T.; Tanaka, T.; Nishimoto, T.; Okuda, K.; Nagata, M.; Burns, D.M.; Yoshie, H. Improved adhesion of human cultured periosteal sheets to a porous poly(L-lactic acid) membrane scaffold without the aid of exogenous adhesion biomolecules. J. Biomed. Mater. Res. A 2011, 98, 100–113. [Google Scholar] [CrossRef] [PubMed]
- Hayashi, H.; Nakahama, K.; Sato, T.; Tuchiya, T.; Asakawa, Y.; Maemura, T.; Tanaka, M.; Morita, M.; Morita, I. The role of Mac-1 (CD11b/CD18) in osteoclast differentiation induced by receptor activator of nuclear factor-kappaB ligand. FEBS Lett. 2008, 582, 3243–3248. [Google Scholar] [CrossRef] [Green Version]
- Ohtsuji, M.; Lin, Q.; Okazaki, H.; Takahashi, K.; Amano, H.; Yagita, H.; Nishimura, H.; Hirose, S. Anti-CD11b antibody treatment suppresses the osteoclast generation, inflammatory cell infiltration, and autoantibody production in arthritis-prone FcγRIIB-deficient mice. Arthritis Res. Ther. 2018, 20, 25. [Google Scholar] [CrossRef] [Green Version]
- Mazzone, A.; Ricevuti, G. Leukocyte CD11/CD18 integrins: Biological and clinical relevance. Haematologica 1995, 80, 161–175. [Google Scholar] [PubMed]
- Sućur, A.; Katavić, V.; Kelava, T.; Jajić, Z.; Kovačić, N.; Grčević, D. Induction of osteoclast progenitors in inflammatory conditions: Key to bone destruction in arthritis. Int. Orthop. 2014, 38, 1893–1903. [Google Scholar] [CrossRef] [PubMed] [Green Version]
- Park-Min, K.H.; Lee, E.Y.; Moskowitz, N.K.; Lim, E.; Lee, S.K.; Lorenzo, J.A.; Huang, C.; Melnick, A.M.; Purdue, P.E.; Goldring, S.R.; et al. Negative regulation of osteoclast precursor differentiation by CD11b and β2 integrin-B-cell lymphoma 6 signaling. J. Bone Miner. Res. 2013, 28, 135–149. [Google Scholar] [CrossRef] [Green Version]
- Madel, M.-B.; Ibáñez, L.; Wakkach, A.; de Vries, T.J.; Teti, A.; Apparailly, F.; Blin-Wakkach, C. Immune Function and Diversity of Osteoclasts in Normal and Pathological Conditions. Front. Immunol. 2019, 10, 1408. [Google Scholar] [CrossRef] [PubMed]
- Horimizu, M.; Kubota, T.; Kawase, T.; Nagata, M.; Kobayashi, M.; Okuda, K.; Nakata, K.; Yoshie, H. Synergistic effects of the combined use of human-cultured periosteal sheets and platelet-rich fibrin on bone regeneration: An animal study. Clin. Exp. Dent. Res. 2017, 3, 134–141. [Google Scholar] [CrossRef] [PubMed] [Green Version]
- Kawase, T.; Yamanaka, K.; Suda, Y.; Kaneko, T.; Okuda, K.; Kogami, H.; Nakayama, H.; Nagata, M.; Wolff, L.F.; Yoshie, H. Collagen-coated poly(L-lactide-co-ɛ-caprolactone) film: A promising scaffold for cultured periosteal sheets. J. Periodontol. 2010, 81, 1653–1662. [Google Scholar] [CrossRef] [PubMed]
- Chatterjea-Matthes, D.; García-Ojeda, M.E.; Dejbakhsh-Jones, S.; Jerabek, L.; Manz, M.G.; Weissman, I.L.; Strober, S. Early defect prethymic in bone marrow T cell progenitors in athymic nu/nu mice. J. Immunol. 2003, 171, 1207–1215. [Google Scholar] [CrossRef] [PubMed] [Green Version]
- Charles_river. BALB/c Nude Mouse Hematology. Available online: https://www.criver.com/sites/default/files/resources/BALBcNudeMouseClinicalPathologyData.pdf (accessed on 3 January 2021).
- Zernecke, A.; Weber, C. Chemokines in atherosclerosis: Proceedings resumed. Arterioscler. Thromb. Vasc. Biol. 2014, 34, 742–750. [Google Scholar] [CrossRef]
- Zhao, Q. Dual targeting of CCR2 and CCR5: Therapeutic potential for immunologic and cardiovascular diseases. J. Leukoc. Biol. 2010, 88, 41–55. [Google Scholar] [CrossRef] [PubMed]
- Heazlewood, S.Y.; Oteiza, A.; Cao, H.; Nilsson, S.K. Analyzing hematopoietic stem cell homing, lodgment, and engraftment to better understand the bone marrow niche. Ann. N.Y. Acad. Sci. 2014, 1310, 119–128. [Google Scholar] [CrossRef]
- Whetton, A.D.; Graham, G.J. Homing and mobilization in the stem cell niche. Trends Cell Biol. 1999, 9, 233–238. [Google Scholar] [CrossRef]
- Ushiki, T.; Huntington, N.D.; Glaser, S.P.; Kiu, H.; Georgiou, A.; Zhang, J.G.; Metcalf, D.; Nicola, N.A.; Roberts, A.W.; Alexander, W.S. Rapid Inflammation in Mice Lacking Both SOCS1 and SOCS3 in Hematopoietic Cells. PLoS ONE 2016, 11, e0162111. [Google Scholar] [CrossRef]
- Kawase, T.; Nagata, M.; Okuda, K.; Ushiki, T.; Fujimoto, Y.; Watanabe, M.; Ito, A.; Nakata, K. Platelet-Rich Fibrin Extract: A Promising Fetal Bovine Serum Alternative in Explant Cultures of Human Periosteal Sheets for Regenerative Therapy. Int. J. Mol. Sci. 2019, 20, 1053. [Google Scholar] [CrossRef] [Green Version]
- Chervenick, P.A.; Boggs, D.R.; Marsh, J.C.; Cartwright, G.E.; Wintrobe, M.M. Quantitative studies of blood and bone marrow neutrophils in normal mice. Am. J. Physiol. 1968, 215, 353–360. [Google Scholar] [CrossRef] [PubMed] [Green Version]
- Burstone, M.S. Histochemical demonstration of acid phosphatases with naphthol AS-phosphates. J. Natl. Cancer Inst. 1958, 21, 523–539. [Google Scholar] [PubMed]
- Kobayashi, M.; Kawase, T.; Okuda, K.; Wolff, L.F.; Yoshie, H. In vitro immunological and biological evaluations of the angiogenic potential of platelet-rich fibrin preparations: A standardized comparison with PRP preparations. Int. J. Implant. Dent. 2015, 1, 31. [Google Scholar] [CrossRef] [Green Version]
- Tsujino, T.; Takahashi, A.; Watanabe, T.; Isobe, K.; Kitamura, Y.; Okuda, K.; Nakata, K.; Kawase, T. Platelet Adhesion on Commercially Pure Titanium Plates in Vitro II. Immunofluorescence Visualization of PDGF-B, TGFβ1, and PPARγ Released from Activated Adherent Platelets. Dent. J. 2019, 7, 109. [Google Scholar] [CrossRef] [PubMed] [Green Version]

| Total | Positive n (%) | P Value | |
|---|---|---|---|
| Medium 199 | 13 | 6 (46.2%) | 0.226 |
| MesenPRO | 12 | 9 (75.0%) |
| Total | Positive n (%) | P Value | |
|---|---|---|---|
| Medium 199 | 13 | 2 (15.4%) | 0.097 |
| MesenPRO | 12 | 6 (50.0%) |
Publisher’s Note: MDPI stays neutral with regard to jurisdictional claims in published maps and institutional affiliations. |
© 2021 by the authors. Licensee MDPI, Basel, Switzerland. This article is an open access article distributed under the terms and conditions of the Creative Commons Attribution (CC BY) license (http://creativecommons.org/licenses/by/4.0/).
Share and Cite
Uematsu, K.; Ushiki, T.; Ishiguro, H.; Ohashi, R.; Tamura, S.; Watanabe, M.; Fujimoto, Y.; Nagata, M.; Ajioka, Y.; Kawase, T. Osteoclastogenic Potential of Tissue-Engineered Periosteal Sheet: Effects of Culture Media on the Ability to Recruit Osteoclast Precursors. Int. J. Mol. Sci. 2021, 22, 2169. https://doi.org/10.3390/ijms22042169
Uematsu K, Ushiki T, Ishiguro H, Ohashi R, Tamura S, Watanabe M, Fujimoto Y, Nagata M, Ajioka Y, Kawase T. Osteoclastogenic Potential of Tissue-Engineered Periosteal Sheet: Effects of Culture Media on the Ability to Recruit Osteoclast Precursors. International Journal of Molecular Sciences. 2021; 22(4):2169. https://doi.org/10.3390/ijms22042169
Chicago/Turabian StyleUematsu, Kohya, Takashi Ushiki, Hajime Ishiguro, Riuko Ohashi, Suguru Tamura, Mari Watanabe, Yoko Fujimoto, Masaki Nagata, Yoichi Ajioka, and Tomoyuki Kawase. 2021. "Osteoclastogenic Potential of Tissue-Engineered Periosteal Sheet: Effects of Culture Media on the Ability to Recruit Osteoclast Precursors" International Journal of Molecular Sciences 22, no. 4: 2169. https://doi.org/10.3390/ijms22042169
APA StyleUematsu, K., Ushiki, T., Ishiguro, H., Ohashi, R., Tamura, S., Watanabe, M., Fujimoto, Y., Nagata, M., Ajioka, Y., & Kawase, T. (2021). Osteoclastogenic Potential of Tissue-Engineered Periosteal Sheet: Effects of Culture Media on the Ability to Recruit Osteoclast Precursors. International Journal of Molecular Sciences, 22(4), 2169. https://doi.org/10.3390/ijms22042169









